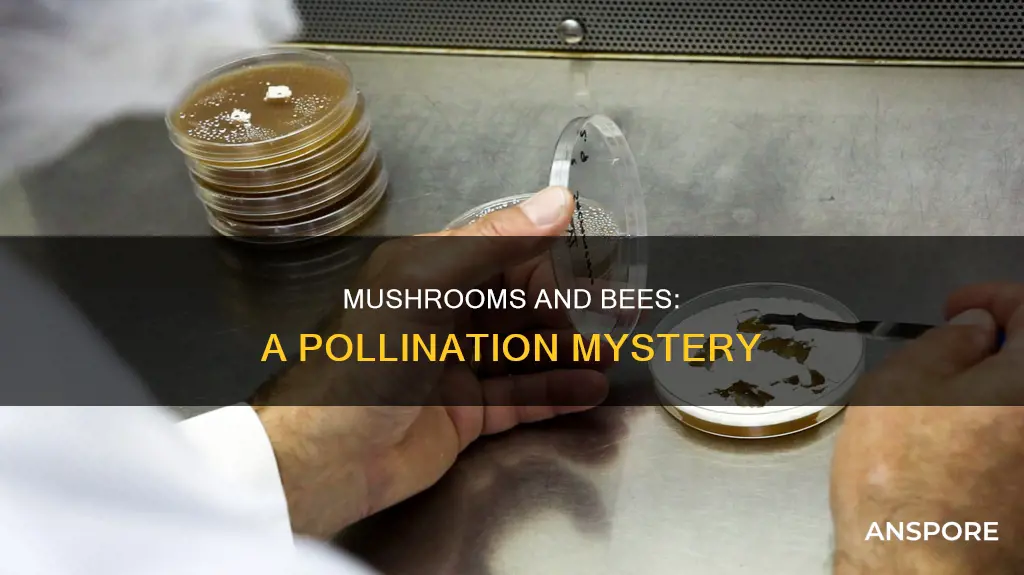
do bees pollinate mushrooms

Bees are essential to the ecosystem, with one-third of the food we consume daily relying on their pollination. However, bee populations are declining due to various factors, including viral infections, which threaten the stability of ecosystems and global food security. In this context, mushrooms have emerged as a possible solution to save the bees. Research has shown that consuming the mycelia of certain mushroom species may strengthen bees' immunity, providing an alternative source of protein and critical nutrients, and reducing virus levels in colonies. Thus, the interconnected relationship between bees and mushrooms is a promising area of study for bee conservation.
| Characteristics | Values |
|---|---|
| Do bees pollinate mushrooms? | No, but mushrooms may save bees. |
| How do mushrooms save bees? | Mushrooms contain antiviral properties that can reduce viruses in bees. |
| What type of mushrooms saves bees? | Polypore mushrooms, Tinder Fungus, and Red Reishi mushrooms. |
| How do bees consume mushrooms? | Bees consume the roots (mycelia) of mushrooms. They also feed on the mushroom mycelium that grows in rotting logs, bark, and soil. |
| Who discovered that mushrooms can save bees? | Paul Stamets, a prominent mycologist, discovered that mushrooms can save bees. |
| Are there any products available to help save bees using mushrooms? | The BeeMushroomed Feeder is a product currently in development that aims to feed local bees with mushroom mycelium extract. |
Explore related products
$14.99 $17.99
What You'll Learn

Mushrooms may be the answer to saving declining bee populations
Bees are essential for pollinating over a third of our food supply and 90% of wild plants. However, bee populations have been declining since the 1980s due to various factors, including pesticides, viruses, and mites. This decline in bee populations has led to concerns about food security and the potential extinction of bees.
The link between bees and mushrooms was first noticed by mushroom farmer and mycologist Paul Stamets, who observed bees sipping on a liquid that had oozed from the mushroom's mycelium. Mycelium is the root-like structure of mushrooms that bees consume, providing them with an alternative source of protein and other nutrients. The mycelial extracts are easily consumed by bees and provide essential nutrition and an immune boost, helping them to ward off infections.
In 2014, Stamets, along with Dr. Steve Sheppard and the Washington State Beekeepers Association, launched BeeFriendly™, an initiative aimed at reversing the decline of the global bee population. Experiments began in 2015, with honey bees drinking different mushroom mycelium extracts, and the results showed promising potential for the health of bee populations.
While further research is ongoing, mushrooms and their extracts may hold the key to supporting the health and nutrition of bees, ultimately helping to save declining bee populations and ensuring the continued pollination of our food supply.
Psychedelic North Spore Mushrooms: What You Need to Know
You may want to see also

Bees use sap from tree bark and stems, fed by mushroom roots
Bees play a crucial role in the ecosystem, with one-third of our daily food relying on their pollination. However, bee populations are declining, and they are facing threats such as climate change, pesticides, parasite infections, and single-crop agriculture. Fortunately, mushrooms may offer a solution to improving bee health and survival rates.
Mushrooms, specifically the polypores, have been found to possess potent antiviral, antioxidant, and anti-inflammatory properties. These extracts can reduce virus levels in bees and improve their overall health. Paul Stamets, a prominent mycologist, observed bees sipping on a liquid oozing from the mycelium of mushrooms growing on fungus-coated wood. This led to his discovery that consuming the roots of certain mushroom species can reduce specific viruses in bees and increase their immunity.
Bees are attracted to the sap found in tree bark and stems, which is indirectly fed by the vast mushroom roots that break down rotten wood. Honeybees, for example, collect sap by scraping it from plants and then chewing it to form propolis, a substance used for building and protecting their hives. Bees use the sap and resins from trees and plants as a natural resource, just as they use nectar and pollen from flowers.
The connection between bees and mushrooms highlights the intricate relationships within the food web and the interdependence of different organisms for survival. By consuming mushroom extracts, bees can strengthen their immunity and ward off infections, ultimately improving their chances of survival. This, in turn, positively impacts the ecosystem and our own food security, as bees are essential pollinators for many plant species.
In addition to their indirect connection through sap, bees also directly consume the roots (mycelia) of mushrooms. These roots provide an alternative source of protein and nutrients for bees, who diligently dig at the base of plants and trees to feed on the spreading mushroom roots. This behaviour further underscores the importance of mushrooms in supporting bee health and nutrition.
Mushroom Mysteries: Spotting Spoiled Fungi
You may want to see also

Mushrooms can reduce viruses in bees
Bees are central to providing food for people, and their health and survival directly impact our survival. In recent years, bee populations have been declining, with U.S. beekeepers reporting that 40% of their hives/colonies died in 2019, a 33% increase from the previous year. This phenomenon is known as "colony collapse disorder," and it is caused by various factors such as climate change, the use of specific pesticides, parasite infections, and the overproduction of single plant crops.
One of the significant contributors to colony collapse disorder is the deformed wing virus (DWV), a devastating virus transmitted by Varroa mites. DWV robs bees of their flight, undermines their immune system, and weakens their ability to pollinate. Infected bees leave traces of the virus on flowers, transmitting the infection to future pollinators. Currently, beekeepers do not have effective means of battling this virus, and the available methods have had limited success.
However, mushrooms may offer a surprising solution to reducing viruses in bees and saving bee populations. Mushrooms are nutrient-dense, containing protein, iron, B-vitamins, and critical nutrients. Bees have been observed foraging on mushroom mycelium, suggesting that they derive medicinal or nutritional value from fungi. Certain mushroom species, such as polypore mushrooms, are known for their potent antiviral properties. Studies have shown that extracts of polypore mushroom mycelia can significantly reduce RNA virus titers, including DWV and Lake Sinai virus (LSV), in honey bees.
Paul Stamets, a prominent mycologist, has been researching the potential of mushrooms in saving bee populations. He first noticed bees in his garden pushing aside bark mulch, and after years of research, he discovered that bees were seeking something in the mushroom mycelium. In collaboration with researchers from Washington State University and the U.S. Department of Agriculture, Stamets conducted experiments where sugar-water feeders were dosed with extracts from various mushroom species, and the effect on infected bees was analyzed. The results showed that bees that fed on mycelium extracts fared significantly better than those that drank only sugar water. In caged bees infected with DWV, an 800-fold decrease in virus titres was observed when dosed with amadou extract.
Mushrooms, therefore, present a promising approach to reducing viruses in bees and helping to mitigate the impacts of colony collapse disorder. By providing bees with access to mushroom mycelium or extracts, we may be able to improve their health, increase their lifespan, and ensure the survival of bee populations, which are crucial for our ecosystems and food systems.
The Size of Coral Mushrooms: How Big Do They Grow?
You may want to see also
Explore related products

Bees are essential for pollinating one-third of our crops
The importance of bees in crop pollination is evident in sub-Saharan Africa, where bee pollination increases cotton yield to 62%, compared to an estimated 37% without their efforts. Similarly, bee pollination in smallholder farming systems in western Kenya has shown dramatic improvements in production rates, contributing to almost 40% of the annual crop production.
The decline in bee populations poses a significant threat to the stability of our food systems. Bees face multiple challenges, including climate change, the use of specific pesticides, parasite infections, and habitat loss due to expanding human land use. These factors negatively impact bee health and survival, which, in turn, affects our food security and survival.
To address these concerns, it is essential to protect bee populations and their habitats. This includes reducing the use of harmful pesticides, increasing crop and regional farm diversity, and promoting targeted habitat conservation and restoration. By taking these steps, we can help ensure the survival of bees and maintain the stability of our food systems.
While bees do not pollinate mushrooms, mushrooms may play a role in saving bee populations. Research has shown that extracts of certain mushroom species, specifically polypores, have potent antiviral properties and can reduce virus levels in bees. By consuming the mycelia of these mushrooms, bees can strengthen their immunity and ward off infections. This connection between bees and fungi highlights the importance of maintaining diverse ecosystems to support bee health and, consequently, the pollination of one-third of our crops.
Jesus and Mushrooms: A Mind-Altering Connection?
You may want to see also

Honey bees are the most important pollinator on Earth
Bees are dying in massive numbers, which is a tragedy given their importance to the ecosystem. It is estimated that one-third of the food that we consume daily relies on the pollination of honeybees. Honeybees are the most frequent floral visitors of crops worldwide, with Apis mellifera averaging 13% of floral visits across all networks. Globally, there are more honeybees than any other type of pollinating insect, making them the most important pollinator on Earth.
Pollinators strongly influence ecological relationships, ecosystem conservation and stability, genetic variation in the plant community, floral diversity, specialisation, and evolution. In tropical forests, woodlands, mangroves, and deciduous forests, many species of plants and animals will not survive if bees disappear. The production of many food sources such as seeds, nuts, berries, and fruits are all highly dependent on insect pollination.
Bees are central to providing food for people, so anything that affects their health and survival will impact our survival. Climate change, the use of specific pesticides, parasite infections, and overproduction of single plant crops that reduce natural plant diversity have all been reported to impact bee survival. Bees are also facing challenges due to habitat loss, disease, parasites, and environmental contaminants, which have contributed to the decline of many pollinator species.
To preserve bees, people can take actions such as planting nectar-bearing flowers like marigolds or sunflowers, buying honey from local beekeepers, raising awareness about the importance of bees, and setting up pollinator farms or gardens. Beekeeping provides an important source of income for many rural livelihoods, and pollinators contribute directly to food security.
While mushrooms do not appear to be directly involved in pollination by bees, they are being touted as a possible solution to declining bee populations. Mushrooms are nutrient-dense, full of protein, iron, B-vitamins, and critical nutrients. Consuming the mycelia of certain mushroom species may strengthen the immunity of bees, helping them to ward off infections.
Mushrooms in Ratatouille: A Tasty Addition?
You may want to see also
Frequently asked questions
No, bees do not pollinate mushrooms. However, bees do consume the roots (mycelia) of fungi, which provide an alternative source of protein to pollen and other plant-derived substances.
Mushrooms are being touted as a possible solution to declining bee populations. Certain mushroom species may strengthen the immunity of bees, helping them ward off infections.
Bees have been observed sipping at a liquid that has oozed from the mushroom's mycelium. They also dig at the base of plants and trees to feed on the mushroom's spreading roots.
Mushrooms may be the answer to saving bee populations. A study revealed that extracts of polypore mushroom mycelia reduced viruses in honey bees.
You can help bees by letting dead logs lay and spreading bark, which will attract mushrooms. This will encourage bees to consume the mushroom mycelium, which may improve their health.

























